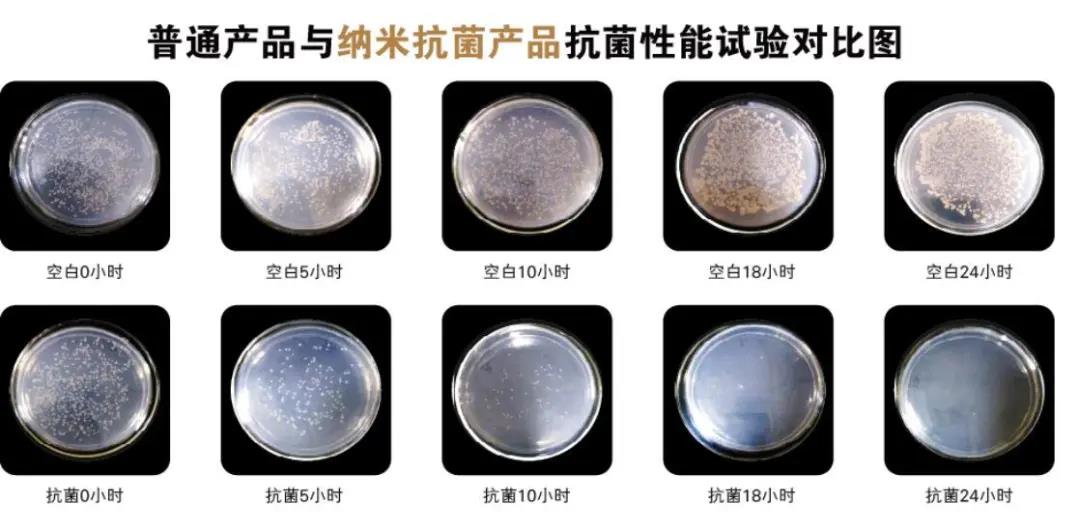
冠军磁砖获得抗菌瓷砖产业化基地授牌荣誉

-

金牌卫浴东莞站经销商会议圆满落幕
6月11日下午,以“携手共进,并肩前行”为主题的金牌卫浴东莞站经销商会议顺利召开。
金牌卫浴 发布时间:2020-06-18 -

金牌卫浴:阜阳质量技术监督局办公楼卫浴洁具安装完毕
办公楼内的金牌卫浴卫生洁具已全部安装完毕并投入使用。
金牌卫浴 发布时间:2020-06-18 -

由摩德娜承建的科乐瓷中板整厂项目正式投产见效
是国内单线产量最大、自动化程度最高的高档中板生产线。
摩德娜 发布时间:2020-06-18 -

华为深圳智能生活馆 X 冠珠魔术师岩板,释放美好生活新势能
华为深圳智能生活采用“场景化”的产品陈列逻辑,地面和墙面选用了目前冠珠陶瓷魔术师岩板。
冠珠 发布时间:2020-06-15 -

由中鹏承建的河北领标科技新型节能超薄岩板项目开线仪式举行
6月11日,广东中鹏热能科技承建的河北领标科技新型节能超薄岩板项目开线仪式隆重举行。
中鹏 发布时间:2020-06-12 -

中盛陶瓷智能展厅焕新呈现,即将璀璨归来【人文篇】
视觉冲击更强,展示更加多样
中盛陶瓷 发布时间:2020-06-12 -
冠军磁砖获得抗菌瓷砖产业化基地授牌荣誉
冠军抗菌砖继荣获CIAA抗菌标识后又获得抗菌领域权威荣誉,被授牌抗菌瓷砖产业化基地。
冠军磁砖 发布时间:2020-06-12 -

瑞阳陶瓷集团获“纳税15强”荣誉称号
瑞阳陶瓷集团获此殊荣,对集团既是肯定,也是鞭策
瑞阳陶瓷 发布时间:2020-06-12














